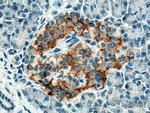
ACVR1C Antibody in Immunohistochemistry (Paraffin) (IHC (P))

Search
Proteintech
ACVR1C Polyclonal Antibody
{{$productOrderCtrl.translations['antibody.pdp.commerceCard.promotion.promotions']}}
{{$productOrderCtrl.translations['antibody.pdp.commerceCard.promotion.viewpromo']}}
{{$productOrderCtrl.translations['antibody.pdp.commerceCard.promotion.promocode']}}: {{promo.promoCode}} {{promo.promoTitle}} {{promo.promoDescription}}. {{$productOrderCtrl.translations['antibody.pdp.commerceCard.promotion.learnmore']}}
产品信息
12610-1-AP
宿主/亚型
分类
类型
抗原
偶联物
形式
浓度
规格
保存条件
运输条件
产品详细信息
Immunogen sequence: RQCSYRKKK RPNVEEPLSE CNLVNAGKTL KDLIYDVTAS GSGSGLPLLV QRTIARTIVL QEIVGKGRFG EVWHGRWCGE DVAVKIFSSR DERYWFREAE IYQTVMLRHE NILGFIAADN KDNGTWTQLW LVSEYHEQGS LYDYLNRNIV TMAGMIKLAL SIASGLAHLH MEIVGTQGKP AIAHRDIKSK NILVKKCETC AIADLGLAVK HDSILNTIDI PQNPKVGTKR YMAPEMLDDT MNVNIFESFK RADIYSVGLV YWEIARRCSV GGIVEEYQLP YYDMVPSDPS IEEMRKVVCD QKFRPSIPNQ WQSCEALRVM GRIMRECWYA NGAARLTALR IKKTISQLCV KEDCKA (139-493 aa encoded by BC022530)
靶标信息
ACVR1C, a serine/threonine protein kinase, is a type I receptor for the TGFB family of signaling molecules. The receptor complex consisting of 2 type II and 2 type I transmembrane serine/threonine kinases. Type II receptors phosphorylate and activate type I receptors which autophosphorylate, then bind and activate SMAD transcriptional regulators, SMAD2 and SMAD3, which then translocate to the nucleus and interact directly with DNA or in complex with other transcription factors. ACVR1C is a receptor for activin AB, activin B and NODAL. This protein plays a role in cell differentiation, growth arrest and apoptosis.
仅用于科研。不用于诊断过程。未经明确授权不得转售。